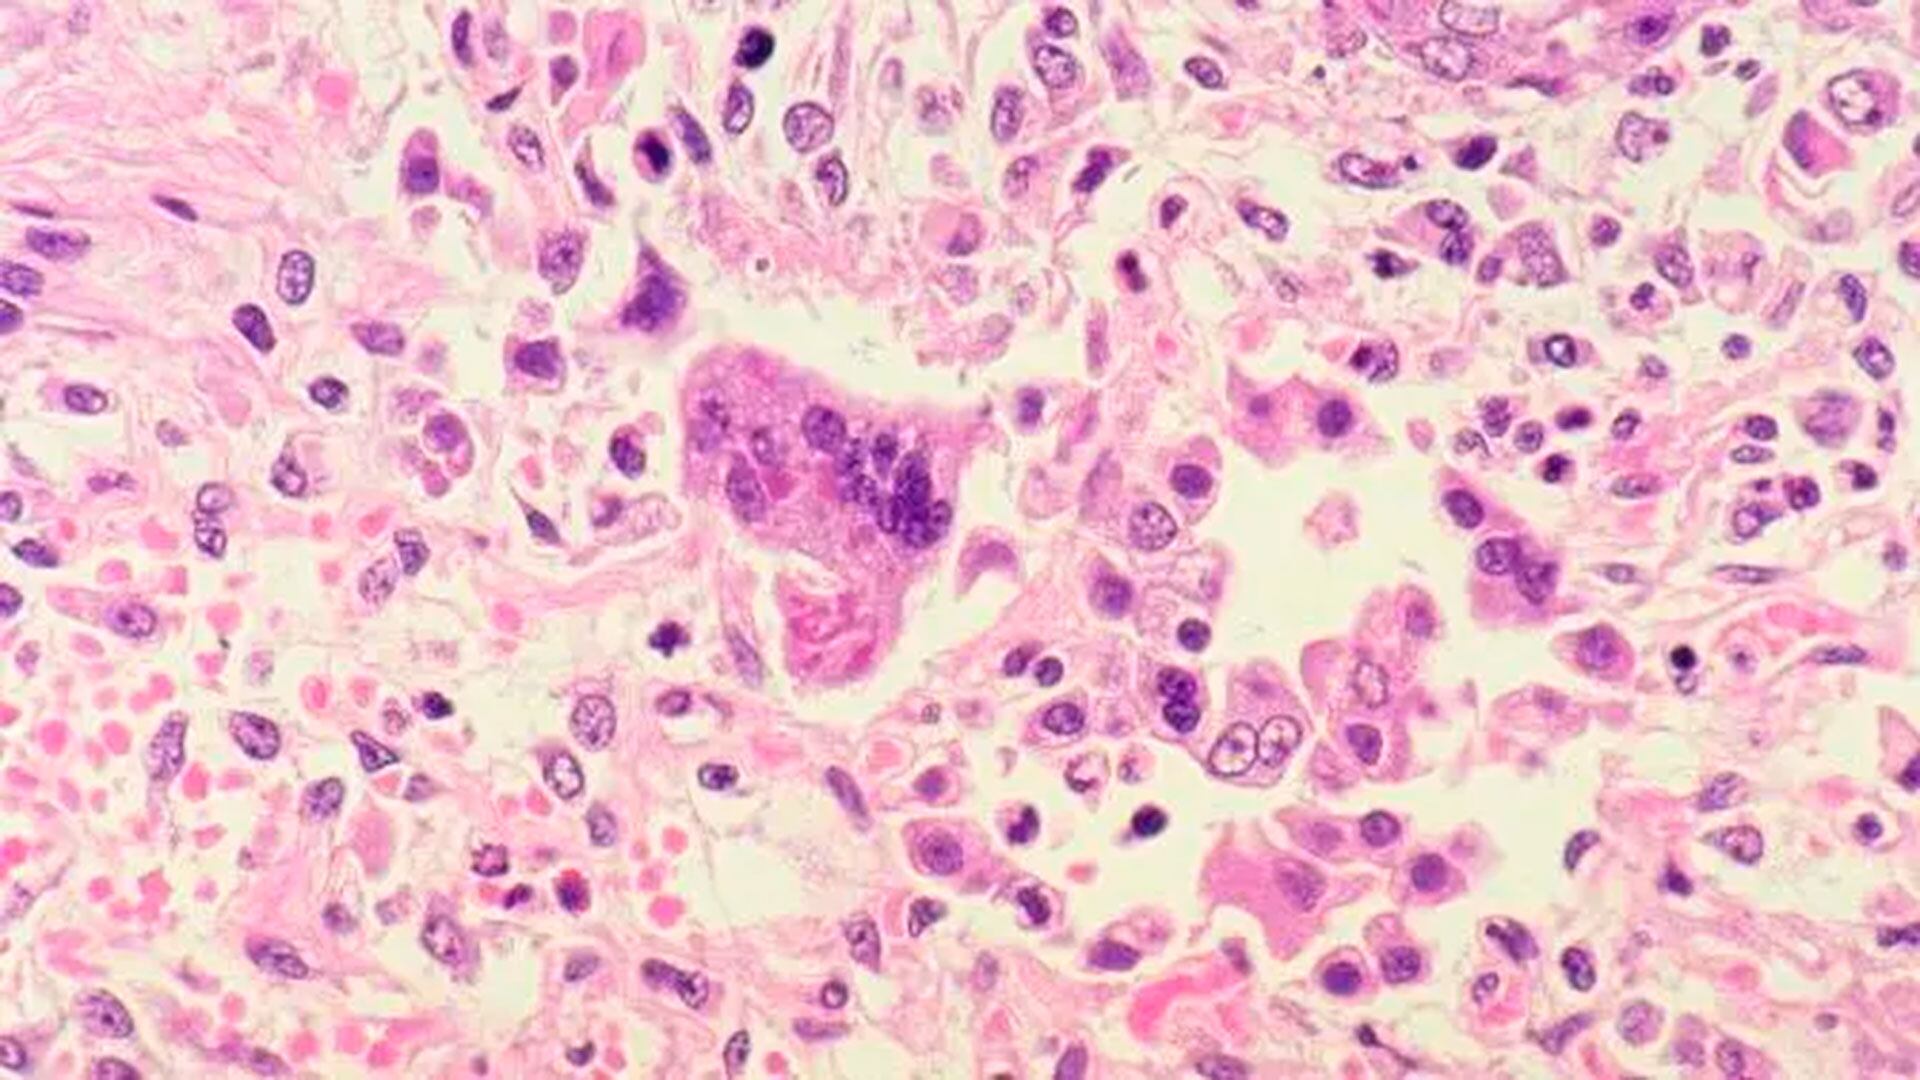
Especialistas advierten que la caída sostenida de la vacunación reabrió la puerta a brotes, un problema que afecta a países de toda la región según la OMS (crédito CDC, EEUU)

Argentina se encuentra bajo una alerta epidemiológica emitida por el Ministerio de Salud de la Nación, después de confirmar que cuatro ciudadanos uruguayos con sarampión, tres adultos y un niño sin antecedentes de vacunación, se desplazaron por la Ciudad de Buenos Aires y siete provincias entre el 14 y el 16 de noviembre.
La familia ingresó desde Bolivia y realizó un extenso recorrido mientras cursaba la enfermedad. La confirmación encendió las alarmas porque ocurrió en medio del brote que desde marzo afecta al Área Metropolitana de Buenos Aires.
La cartera sanitaria explicó que “la medida busca identificar rápidamente a quienes pudieron haber estado expuestos en los diversos trayectos de su recorrido y reforzar la vigilancia de enfermedad febril exantemática (EFE) en todas las jurisdicciones”.

Las autoridades iniciaron la reconstrucción completa de los itinerarios, la identificación de contactos y el refuerzo de la notificación inmediata ante cualquier sospecha.
Este episodio se sumó a un escenario sensible. Argentina mantiene el estatus de eliminación del sarampión desde el año 2000, aunque los brotes vinculados a personas no vacunadas y a viajeros internacionales se volvieron más frecuentes en la región y el país registró 35 casos confirmados hasta la semana epidemiológica 26 de 2025.
La situación coincidió con un brote sostenido en el AMBA de las últimas semanas, donde la baja cobertura de vacunación infantil obligó a lanzar una campaña extraordinaria dirigida a más de 620.000 niños y niñas de entre 6 meses y 4 años.
¿Qué es el sarampión y qué lo provoca?

El sarampión es una enfermedad viral exantemática que pertenece a la familia Paramyxoviridae. Provoca fiebre, erupción cutánea y un compromiso general que puede ser grave, en especial en niños pequeños y en personas desnutridas.
El virus se transmite por las vías respiratorias y posee una capacidad de diseminación que supera a la mayoría de los agentes infecciosos conocidos.

No existe un antiviral específico capaz de detener la infección. La evolución depende del estado inmunológico del paciente y de la atención médica oportuna. La vacunación demuestra una eficacia del 95% y constituye la herramienta central para evitar casos graves, brotes y muertes.
¿Por qué el sarampión es tan contagioso?
El sarampión ocupa el podio de los virus con mayor capacidad de transmisión. Los Centros para el Control y la Prevención de Enfermedades de EEUU indican que si una persona desarrolla la infección, hasta el 90% de quienes no poseen inmunidad enferman si comparten el mismo aire o tocan superficies contaminadas. Este comportamiento explica por qué la enfermedad se expande con tanta facilidad incluso cuando los síntomas todavía no comenzaron.
Unicef profundizó esta característica al señalar que “por cada persona que tiene sarampión, entre 12 y 18 personas más se infectan. Esto hace que el sarampión sea alrededor de 12 veces más contagioso que la gripe, seis veces más contagioso que el ébola y el doble que el COVID-19 y la varicela”.
La combinación de transmisibilidad extrema y baja vacunación genera escenarios de riesgo incluso en países que mantienen la eliminación endémica.
¿Cómo se propaga el sarampión?

El virus del sarampión reside en las mucosas respiratorias. El doctor Peter Hotez de la Universidad de Yale lo describió así: “El virus del sarampión vive en las mucosidades de la nariz y la garganta de las personas infectadas. Cuando tosen, estornudan o respiran, las partículas virales se lanzan al aire, donde pueden permanecer hasta dos horas”. Esa permanencia significa que el contagio no requiere contacto directo.
Hotez agregó: “Ni siquiera es necesario tener contacto directo o cercano con una persona infectada para enfermarse. También es posible contraer la enfermedad al tocar superficies contaminadas con el virus y luego llevarse las manos a la boca, nariz u ojos. Por eso el sarampión es uno de los virus más contagiosos que conocemos”.
Las personas infectadas transmiten el virus desde cuatro días antes de la aparición del exantema hasta cuatro días después. La duración del curso completo suele extenderse entre una semana y diez días. Esta ventana de transmisión silenciosa vuelve difícil el control en entornos con circulación intensa de viajeros o con baja vacunación.
¿Cuáles son los síntomas del sarampión?

Los primeros signos suelen confundirse con una infección respiratoria común. El virus ingresa por las vías aéreas y provoca fiebre alta, tos seca, congestión nasal y conjuntivitis. Estos síntomas aparecen entre una y dos semanas después del contacto con el virus, por lo que muchas personas continúan con su vida habitual mientras contagian.
La fase siguiente incluye la erupción cutánea clásica. Comienza en la cara y avanza hacia el cuello, el tronco y las extremidades. Otra señal típica es la presencia de las manchas de Koplik, pequeñas lesiones blancas en la mucosa bucal.
Los CDC describieron esta evolución así: “De tres a cinco días después, es posible que aparezca el sarpullido clásico: manchas rojas en la cara que salpican la línea del cabello y luego se extienden al cuello, el tronco, los brazos, las piernas y los pies. Cuanto más oscura sea la piel, más probabilidades hay de que aparezcan pequeñas protuberancias elevadas en las mismas áreas sin decoloración. Aunque parece doloroso, el sarpullido del sarampión no suele causar picazón”.

Mayo Clinic detalló la última etapa: “El sarpullido del sarampión puede durar hasta siete días y luego disminuye progresivamente; primero desaparece del rostro y, por último, de los muslos y los pies. Si bien otros síntomas de la enfermedad desaparecen, la tos y el oscurecimiento o la descamación de la piel donde estaba el sarpullido pueden durar hasta 10 días”.
Las complicaciones afectan sobre todo a menores de cinco años. Unicef recordó que “uno de cada 20 niños menores de 5 años con sarampión desarrolla neumonía, uno cada 1.000 va a tener encefalitis y hasta tres de cada 1.000 niños puede fallecer por sarampión”. Además, quienes superan la infección quedan expuestos a una encefalitis tardía décadas después.

¿Qué complicaciones y casos graves puede acarrear?
Entre las complicaciones del sarampión, Mayo Clinic describe las siguientes:
· Diarrea y vómitos. La diarrea y los vómitos pueden provocar que el cuerpo pierda una cantidad excesiva de agua (deshidratación).
· Infección de oído. Una de las complicaciones más frecuentes del sarampión es la infección bacteriana del oído.
· Bronquitis, laringitis o crup. El sarampión puede provocar la irritación e hinchazón (inflamación) de las vías respiratorias (crup). También puede causar la inflamación de las paredes internas que alinean las principales vías de paso de aire de los pulmones (bronquitis). Además, el sarampión puede provocar la inflamación de la laringe (laringitis).
· Neumonía. Con frecuencia, el sarampión puede provocar una infección en los pulmones (neumonía). Las personas que tienen el sistema inmunitario debilitado pueden padecer una variedad especialmente peligrosa de neumonía que, a veces, puede ser mortal.
· Encefalitis. Aproximadamente, 1 de cada 1000 personas con sarampión puede presentar una complicación llamada “encefalitis”, que es la irritación e hinchazón (inflamación) del cerebro. Esta afección puede ser especialmente peligrosa para aquellas personas que tienen el sistema inmunitario debilitado. Puede manifestarse muy poco después de haber contraído sarampión o después de varios meses y puede causar daño cerebral permanente.
· Problemas durante el embarazo. Si se está embarazada, se debe tener mucho cuidado de no contagiarse sarampión porque esta enfermedad puede provocar un parto prematuro, bajo peso del bebé al nacer o la muerte del feto.

¿Cómo se previene el sarampión?
La prevención depende casi por completo de la vacunación. La vacuna triple viral, incluida en el Calendario Nacional, reduce en un 95% la posibilidad de desarrollar la enfermedad. Los especialistas insisten en que ningún país mantiene la eliminación del virus sin coberturas superiores al 95% en la población infantil.
El doctor Ricardo Teijeiro resumió el riesgo: “En Argentina teníamos el sarampión controlado hasta el año 2000. Cuando empiezan a bajar las coberturas, se incrementa el riesgo de reintroducción del virus”. Y advirtió: “La gente creyó que como no había sarampión podía dejar de vacunarse. En realidad es todo lo contrario”.
Las autoridades recomendaron que quienes compartieron viaje o estuvieron en los puntos visitados por la familia uruguaya y presenten síntomas hasta el 12 de diciembre consulten de inmediato y mencionen el antecedente de exposición.

Quiénes deben vacunarse contra el sarampión
Todas las personas desde el año de vida deben contar con el esquema completo de vacunación contra sarampión y rubéola mediante dos dosis de vacuna triple viral.
Durante el brote del AMBA, el Ministerio de Salud definió medidas específicas según edad y residencia:
- De 6 a 11 meses que viven en el AMBA: una dosis de doble viral como dosis cero.
- A los 12 meses: la dosis del calendario y una adicional un mes más tarde.
- De 13 meses a 4 años y 11 meses: una dosis adicional de doble viral.
- A los 5 años: la dosis del calendario.
- Niños mayores de 13 meses sin vacunación previa: una triple viral y luego una doble viral con 28 días de diferencia.
- Personal de salud: dos dosis aplicadas después del año de vida o serología positiva.

Las jurisdicciones del AMBA reforzaron la accesibilidad con campañas en contraturno, vacunatorios ampliados los fines de semana, unidades móviles y operativos escolares para revisar libretas y completar esquemas.